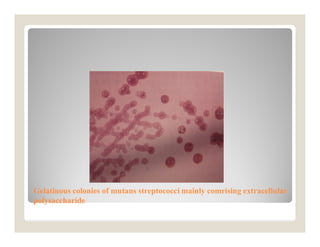
Endodontic microflora

38 propi-star ec label
Product Catalogue | Kenso Agcare Australia CLETHO 360 EC: 360 g/L CLETHODIM: 5L, 20L, 110L, 1,000LGroupA COSSACK 745 SL: 745 g/L FLUPROPANATE present as the SODIUM SALT ... KEN-STAR 450: 450 g/L 2,4-D as the ISOPROPYLAMINE SALT: 20L, 110L, 1,000LGroupI KEN-TREL 300: 300 g/L CLOPYRALID present as the TRIISOPROPANOLAMINE SALT ... PROPI 250: 250 g/L PROPICONAZOLE: 5L, 20L, 110LGroup3 PROPI ... PPZ 41.8 Select - Where to buy PPZ 41.8 Select Fungicide Propiconazole ... We may ship either PPZ 41.8 Select (Prim Source Brand) or Propi-Star EC (Albaugh Brand) depends on the current stock & availibility. Both are same product, just different manufacturer. PPZ_41.8_Select_Label.pdf PPZ_41.8_Select_Label of PPZ 41.8 Select Fungicide Propiconazole - Gal PPZ_41.8_Select_MSDS.pdf
Labels & SDS - Sharda USA Label SDS HERBICIDES PRODUCTS 70 VIEW ALL INSECTICIDES PRODUCTS 15 VIEW ALL. OTHER PRODUCTS 4 VIEW ALL. NEWS & EVENTS View All. Apr 30-20 Sharda Products Now listed on Xtendimax & Engenia Sharda Cropchem, Ltd is pleased to announce the following products are now listed on the Xtendimax and Engenia websites: *Bashazon - newly added as of 4/13 ...
Propi-star ec label
Home - Label Database - CDMS Propi-Star® EC PROPICONAZOLE 42750-211. QuinStar® QUINCLORAC 42750-88 ... QUINCLORAC 42750-169. Range Star® DICAMBA + 2,4-D 42750-55 ... Propi-Star® EC - Albaugh - Knowde Propi-Star® EC is an effective broad-spectrum fungicide for the control of many foliar and soilborne diseases on cereals, corn, vegetables, commercial Preview For buyers For producers Security Products - Albaugh North America Products. 2,4-D Amine 4 is used for selective control of many broadleaf weeds in certain crops, including, cereal grains (wheat, barley, millet, oats and rye), corn (field corn, popcorn and sweet corn), fallow land and crop stubble, rice, sorghum (grain and forage sorghum), soybeans (preplant burndown application only); forests; rangeland and ...
Propi-star ec label. Shop | FBN Propi-Star® EC Product label This product used for comparison purposes only and not available for purchase on FBN. Product details Resources Instructions Label Safety Data Sheet Price Transparency Become a Member to See What Other Farmers Are Paying for Inputs Prices you submit will never be exposed to other farmers. Propi-Star® EC - Reichman Sales & Service Reichman Sales & Service PO Box 698 - Toluca, IL 61369 Phone: 815-452-2665 Fax: 815-452-2837 PDF GlyStar Plus - Agrian EPA Reg. No. 42750-61 EPA Est. No. 42750-MO-1 KEEP OUT OF REACH OF CHILDREN CAUTION FIRST AID IF IN EYES:• Hold eye open and rinse slowly and gently with water for 15-20 minutes. • Remove contact lenses, if present, after the first 5 minutes, then continue rinsing eye. • Call a poison control center or doctor for treatment advice. Propi-Star® EC | Van Diest Supply Company Propi-Star ® EC. Broad-spectrum fungicide for control of plant, turf and ornamental diseases. ACTIVE INGREDIENTS: Propiconazole: 41.8% INERT INGREDIENTS: 58.2% TOTAL: 100.0% . Propi-Star® EC contains 3.6 pounds per gallon of propiconazole. EPA Registration No. 42750-211. View Label: View SDS: Van Diest Supply Company. Shipping Address. 1434 ...
PDF Chemical Safety and Pollution Prevention - Us Epa The Agency acknowledges your request for the alternate brand name "PROPI-STAR 4E". The label submitted with the application has been stamped "Notification" and will be placed in our records. If you have any questions, please contact Robert Westin by phone at (703) 30S-S721 or via email at westin.robert@epa.gov. Sincerely, .IJ'A_q~ Protégé - Atticus LLC Protégé™ uses the fast-acting fungicidal power of azoxystrobin and difenoconazole to bring disease control and improved plant performance to golf course turf areas. The dual modes of action work together to give resistance management protection and broad-spectrum control in IPM programs. Protégé is an ideal tool for golf course turf areas ... Agri Star Dicamba HD - Lawn & Landscape Agri Star Dicamba HD is an effective herbicide for weed control in conservation reserve programs, rangeland, forestry sites, golf course greens and tees, and many other non-crop areas. ... , and many other non-crop areas. Related. Agri Star 2,4-D Amine 4 Herbicide. Agri Star 2,4-D LV4 Low Volatile Herbicide. Agri Star Propi-Star EC. Lawn ... American Mushroom Institute - Wood Preservatives Label. Propi-Star® EC Active ingredient: propiconazole. Safetray P Active ingredient: propiconazole L abel SDS. The above list of chemicals is designed for informational purposes and is not an endorsement of any product. In some cases, particularly those where the active ingredient is no longer protected by the patent, and a number of similar ...
PDF LABEL PROPI-STAR EC - Amazon Web Services SPECIMEN LABEL PROPI-STAR®EC Fungicide Broad spectrum fungicide for control of plant, turf and ornamental diseases Manufactured for: ALBAUGH, LLC 1525 NE 36th Street Ankeny, Iowa 50021 FOR CHEMICAL SPILL, LEAK, FIRE, OR EXPOSURE, CALL CHEMTREC (800) 424-9300 PDF PROPI-STAR EC - Amazon Web Services PROPI-STAR™ EC is a broad-spectrum fungicide labeled for the control of many diseases. FAILURE TO FOLLOW DIRECTIONS AND PRECAUTIONS ON THIS LABEL MAY RESULT IN CROP INJURY, POOR DISEASE CONTROL, OR ILLEGAL RESIDUES. PRODUCT USE PRECAUTIONS Important: Do not use PROPI-STAR™ EC in greenhouses or as a tree injection. Propi-Star EC | Albaugh, LLC | Agworld DBX | Greenbook View the product label for Propi-Star EC from Albaugh, LLC. See active ingredients, product application, restrictions, and more at Agworld DBX, powered by Greenbook ... Propi-Star EC Albaugh, LLC. Labels. Label SDS. Snapshot ID: 52437 Active ingredients Propiconazole Classification. 3. Fungicide. WSSA mode of action C14-demethylation in sterol ... All Products - Regal Safe to fish. Refer to label for application rates. May be used in irrigation and potable water. Liquid. K-TEA. Chelated copper for aquatic algae control. Liquid. Komen® Komen® aquatic herbicide is ideal for quick, targeted control of nuisance submerged and floating aquatic weeds. ... Propi-Star® 41% EC. A concentrated formulation of ...
PDF Cleanse Tm 2 Ec - Cdms Cleanse 2 EC Contains 2.0 lbs. clethodim per gal. KEEP OUT OF REACH OF CHILDREN WARNING - AVISO ... Have the product container or label with you when calling a poison control center or doctor, or going for treatment. For information on this product, contact the National Pesticide Information Center, 1-800-858-7378, Monday-Friday, 7:30 AM-3:30 ...
PDF MATERIAL SAFETY DATA SHEET - Agrian (800) 424-9300 (CHEMTREC, transportation and spills) Ankeny, IA 50021 PRODUCT NAME: PROPI-STAR EC CHEMICAL NAME: Propiconazole, 1-((2-(2,4-Dichlorophenyl)-4-propyl-1,3-dioxolan-2-yl)methyl)-1H-1,2,4 triazole CHEMICAL FAMILY: Triazole fungicide PRODUCT CODE: EPA Reg. No 42750-211 SECTION 2 - COMPOSITION, INFORMATION OF INGREDIENTS
PDF Chemical Safety and Pollution Prevention - Us Epa
Search for Pesticide Products - California PROPICONAZOLE (2276) Active Chemicals only 104 product labels match. Any product listed below, which includes the term "Master Label" in front of the product brand name, may not be sold or used in California. Put a check by all the products you would like more details on.
PDF Propi-Star EC Propi-Star® EC can be applied up to 45 days prior to harvest. Foot Rot (Pseudocercosporella spp.) 4 Apply Propi-Star® EC plus half rates of other EPA registered fungicides such as Topsin® M. Apply at tillering, but before elongation has occurred. Fusarium Head Blight Suppression 4 Apply Propi-Star® EC at approximately 50% flowering ...
10062152 Net Contents: 1 Gallon #291548 - SiteOne Have the product container or label with you when calling a poison control center or doctor, or going for treatment. You may also contact: CHEMTREC for transportation and spills (800) 424-9300. PROSAR for human health & animal health (800) 331-3148. This product is a pyrethroid. If large amounts have been ingested, the stomach and
Bumper® 41.8 EC Fungicide - Reichman Sales & Service Bumper® 41.8 EC is a broad spectrum fungicide for the control of specified diseases in labeled crops. Do not use this product in greenhouses or as a tree injection. Bumper is a registered trademark of Makhteshim Agan of North America, Inc. Disclaimer: Purchaser is responsible to read the Product Label and Use requirements for this product.
Search for Pesticide Products Chemicals: PROPICONAZOLE (2276) 231 product labels match. Any product listed below, which includes the term "Master Label" in front of the product brand name, may not be sold or used in California. Put a check by all the products you would like more details on. Then, select the report format you want from the list below and press the Report button.
Propi-Star EC - Fungicide - 1 Gal — Earth Products LLC Propi-Star EC - Fungicide - 1 Gal 105.79 Propi-Star EC Fungicide is a broad-spectrum fungicide that is made to control a wide range of diseases in turf and ornamentals.
Products - VDSC Propi-Star ® EC. Broad-spectrum fungicide for control of plant, turf and ornamental diseases. ACTIVE INGREDIENTS: Propiconazole: 41.8% INERT INGREDIENTS: 58.2% TOTAL: 100.0%. Propi-Star ® EC contains 3.6 pounds per gallon of propiconazole. EPA Registration No. 42750-211. View Label | View SDS
PDF AG Triclopyr 3 Specimen Label - Alligare Have the product container or label with you when Pcalling a poison control center or doctor, or going for treatment. You may also contact 1-800-424-9300 for emergency medical treatment information. NOTE TO APPLICATOR: Allergic skin reaction is not expected from exposure to spray solutions of Alligare Triclopyr 3 herbicide when used as directed.
Products - Albaugh North America Products. 2,4-D Amine 4 is used for selective control of many broadleaf weeds in certain crops, including, cereal grains (wheat, barley, millet, oats and rye), corn (field corn, popcorn and sweet corn), fallow land and crop stubble, rice, sorghum (grain and forage sorghum), soybeans (preplant burndown application only); forests; rangeland and ...
Propi-Star® EC - Albaugh - Knowde Propi-Star® EC is an effective broad-spectrum fungicide for the control of many foliar and soilborne diseases on cereals, corn, vegetables, commercial Preview For buyers For producers Security
Home - Label Database - CDMS Propi-Star® EC PROPICONAZOLE 42750-211. QuinStar® QUINCLORAC 42750-88 ... QUINCLORAC 42750-169. Range Star® DICAMBA + 2,4-D 42750-55 ...

Post a Comment for "38 propi-star ec label"